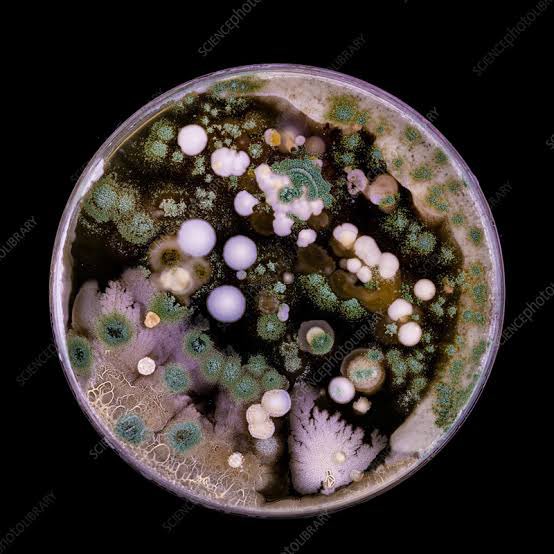
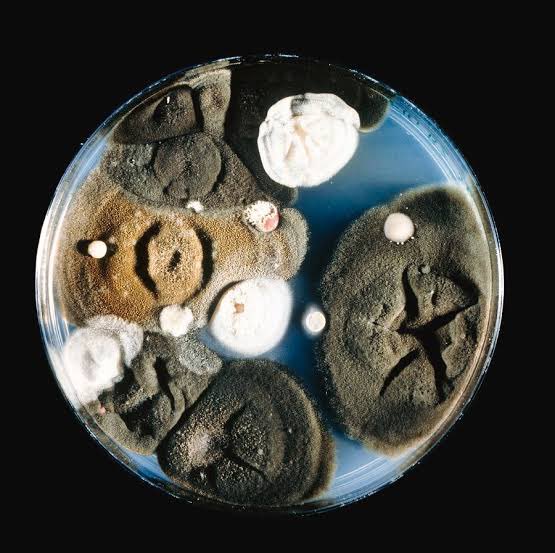

هل التجميد يقتل البكتيريا⁉️
تجميد الأغذية من الطرق التي يلجأ لها الكثير من الناس لقتل البكتيريا والأحياء الدقيقة في الطعام
ولكن ما لا يعرفوه أن تجميد الأغذية لا يقتل البكتريا والأحياء الدقيقة إنما يثبط عملها ويمنع تكاثرها، فعند إزالة التجميد تعود البكتيريا والأحياء الدقيقة للتكاثر لذلك ينصح بعد إزالة التجميد بعدم جواز إعادة تجميدها بل تحضيرها لكي تتجنب التسمم الغذائي
تجميد الأغذية من الطرق التي يلجأ لها الكثير من الناس لقتل البكتيريا والأحياء الدقيقة في الطعام
ولكن ما لا يعرفوه أن تجميد الأغذية لا يقتل البكتريا والأحياء الدقيقة إنما يثبط عملها ويمنع تكاثرها، فعند إزالة التجميد تعود البكتيريا والأحياء الدقيقة للتكاثر لذلك ينصح بعد إزالة التجميد بعدم جواز إعادة تجميدها بل تحضيرها لكي تتجنب التسمم الغذائي
جاري تحميل الاقتراحات...